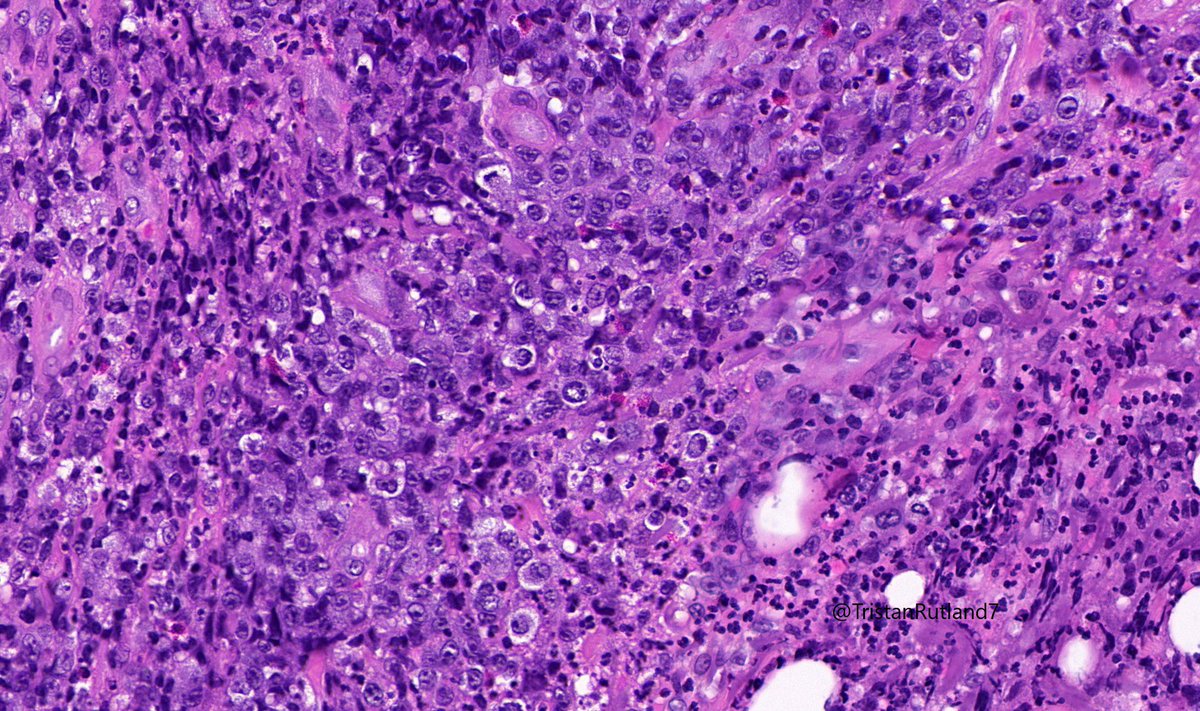
Female, adult, leg.  @ZHOUSEH  @MattieFarzin  @rennmont  @DrJPLow  @JMGardnerMD  @DrGeeONE  @Kashifhazim  @Divya_Madhala  @Meghna0630  @ariella8  @pembeoltulu  @MAHoureih  @ChristineJKoMD  @rdpatho   #dermpath  #pathtwitter  #pathology
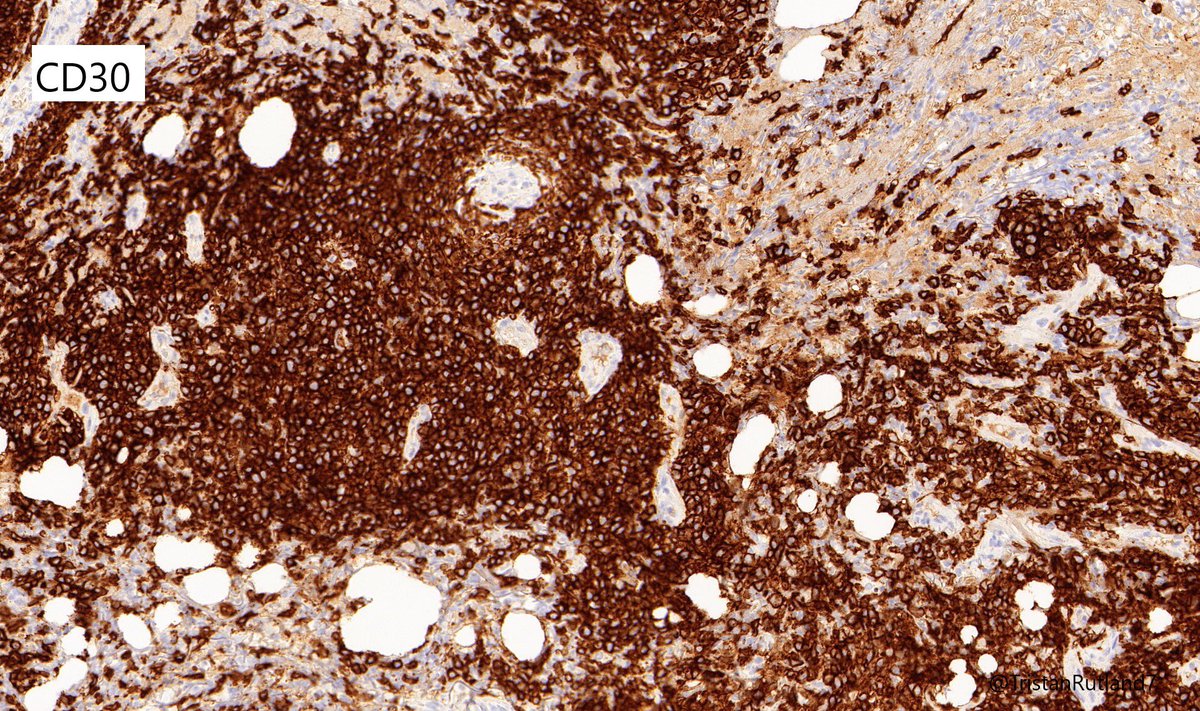
CD30
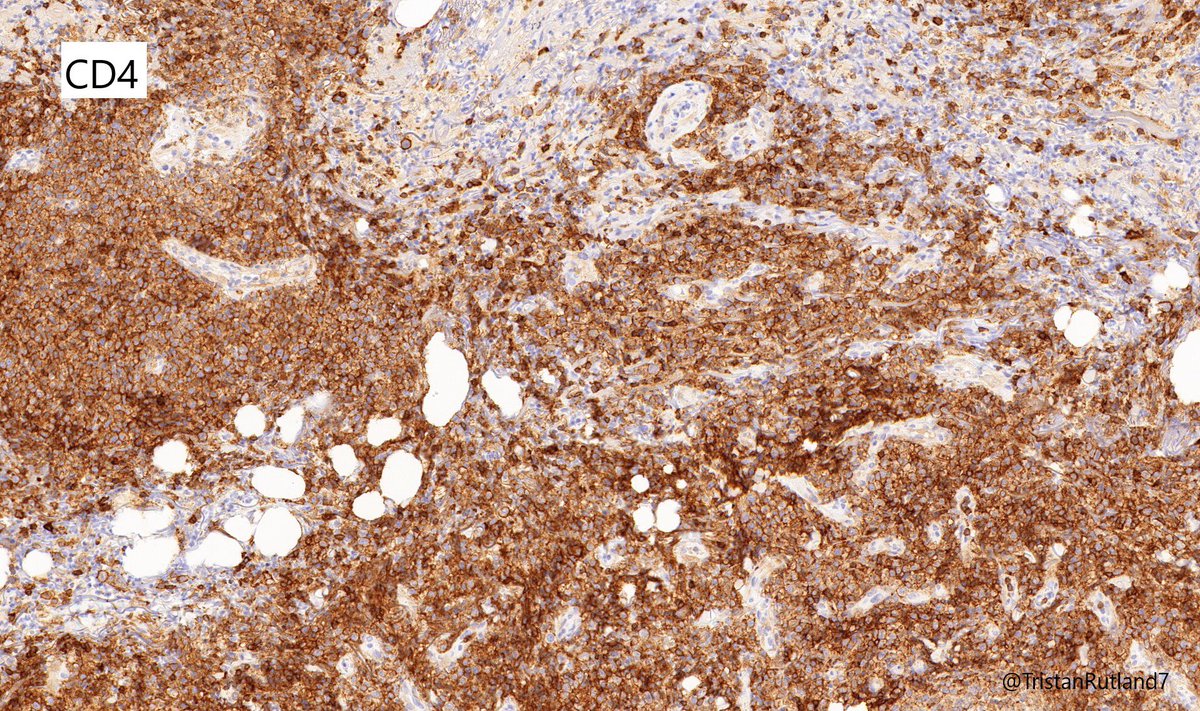
CD4

Female, adult, leg.
@ZHOUSEH @MattieFarzin @rennmont @DrJPLow @JMGardnerMD @DrGeeONE @Kashifhazim @Divya_Madhala @Meghna0630 @ariella8 @pembeoltulu @MAHoureih @ChristineJKoMD @rdpatho
#dermpath #pathtwitter #pathology
@ZHOUSEH @MattieFarzin @rennmont @DrJPLow @JMGardnerMD @DrGeeONE @Kashifhazim @Divya_Madhala @Meghna0630 @ariella8 @pembeoltulu @MAHoureih @ChristineJKoMD @rdpatho
#dermpath #pathtwitter #pathology
Diagnosis:
Large cell transformation of mycosis fungoides (MF).
#Hemepath
This was a colleague’s case.
Large cell transformation of mycosis fungoides (MF).
#Hemepath
This was a colleague’s case.
1/ Mycosis fungoides (MF) is a cutaneous T-cell lymphoma and has a range of stages:
Patch & plaque stage indolent
indolent
Tumour stage worse prognosis
worse prognosis
2/ It usually expresses mature T cell phenotype CD4 (but v rare CD8 cases can occur).
https://pubmed.ncbi.nlm.nih.gov/10071312
Patch & plaque stage
 indolent
indolentTumour stage
 worse prognosis
worse prognosis2/ It usually expresses mature T cell phenotype CD4 (but v rare CD8 cases can occur).
https://pubmed.ncbi.nlm.nih.gov/10071312
2b/ In regards to staging, I have attached an excellent article below.
https://ashpublications.org/blood/article/110/6/1713/24087/Revisions-to-the-staging-and-classification-of
https://ashpublications.org/blood/article/110/6/1713/24087/Revisions-to-the-staging-and-classification-of
3/ Large cell transformation is defined by greater than 25% large cells (4X size normal lymphocytes) or nodular aggregates in dermis.
4/ It usually arises from tumour stage (rare cases arising from patch stage have occurred).
https://pubmed.ncbi.nlm.nih.gov/10733487/
4/ It usually arises from tumour stage (rare cases arising from patch stage have occurred).
https://pubmed.ncbi.nlm.nih.gov/10733487/
5/ CD30 is NOT a marker for transformation (can be found in patch stage), but might provide a target from treatment.
https://pubmed.ncbi.nlm.nih.gov/21047225/
https://pubmed.ncbi.nlm.nih.gov/21047225/
6/ Differential diagnosis that need to be considered:
 Primary cutaneous anaplastic large cell lymphoma (PCALCL)
Primary cutaneous anaplastic large cell lymphoma (PCALCL)
 Lymphomatoid papulosis (LyP)
Lymphomatoid papulosis (LyP)
Hx is absolutely essential in these situations (ie previous MF).
(?GATA3 may be helpful sometimes?).
https://pubmed.ncbi.nlm.nih.gov/25440432/
 Primary cutaneous anaplastic large cell lymphoma (PCALCL)
Primary cutaneous anaplastic large cell lymphoma (PCALCL) Lymphomatoid papulosis (LyP)
Lymphomatoid papulosis (LyP)Hx is absolutely essential in these situations (ie previous MF).
(?GATA3 may be helpful sometimes?).
https://pubmed.ncbi.nlm.nih.gov/25440432/
7/ Lastly, 25% of MF can be associated LyP….
https://pubmed.ncbi.nlm.nih.gov/14512906/
https://pubmed.ncbi.nlm.nih.gov/14512906/

 Read on Twitter
Read on Twitter